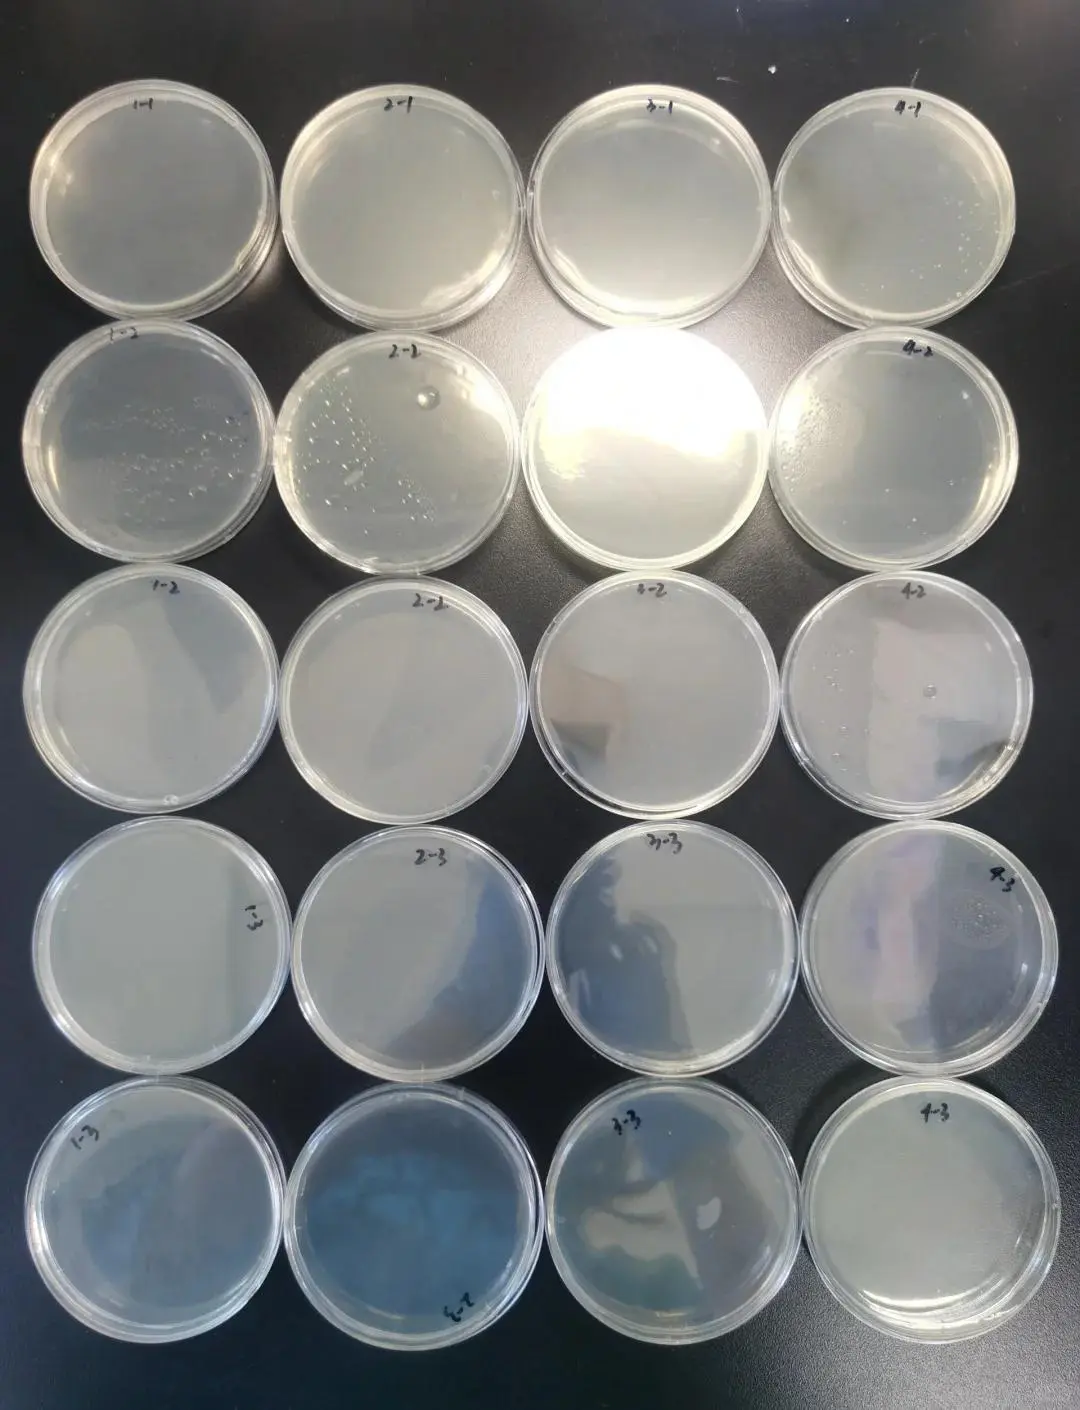
什么是抗菌面料？
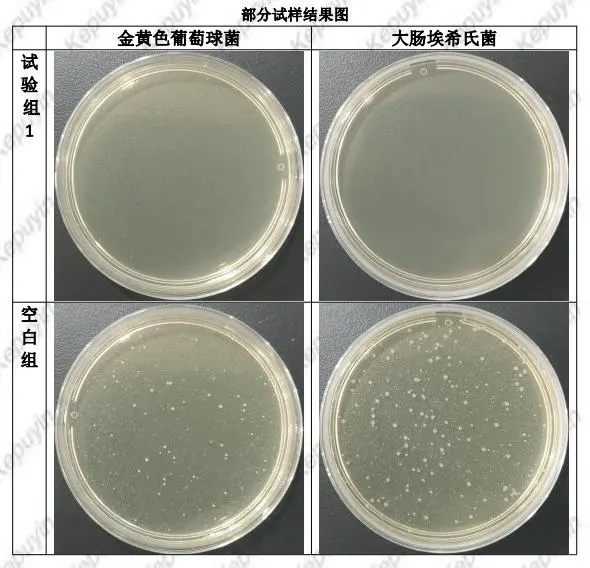
什么是抗菌面料？

抗菌检测是用于评估材料、产品或物质抑制、杀灭细菌等微生物能力的试验,广泛应用于医疗、日化、纺织等领域。
常见检测对象
- 各类抗菌材料:如抗菌塑料、抗菌纤维、抗菌涂料等。
- 抗菌产品:包括消毒剂、抗菌洗涤剂、抗菌医疗器械等。
- 纺织品:如抗菌口罩、抗菌衣物等。
主要检测方法
- 抑菌圈法:将待检测样品置于含菌培养基上,培养后观察样品周围是否形成无菌的抑菌圈,通过圈的大小判断抗菌效果。
- 菌落计数法:检测样品作用前后微生物的菌落数量变化,计算抑菌率或杀菌率,常用的有振荡烧瓶法、接触法等。
- 最小抑菌浓度(MIC)测定:通过系列稀释法确定能抑制微生物生长的最低药物浓度。
不同产品需依据相应国家标准(如GB/T 20944系列)选择合适的检测方法,以确保结果的准确性和可靠性。
#检测报告 #检测 #CNAS #抑菌 #杀菌 #针织面料 #细菌 #第三方检测 #检测机构 #纺织
常见检测对象
- 各类抗菌材料:如抗菌塑料、抗菌纤维、抗菌涂料等。
- 抗菌产品:包括消毒剂、抗菌洗涤剂、抗菌医疗器械等。
- 纺织品:如抗菌口罩、抗菌衣物等。
主要检测方法
- 抑菌圈法:将待检测样品置于含菌培养基上,培养后观察样品周围是否形成无菌的抑菌圈,通过圈的大小判断抗菌效果。
- 菌落计数法:检测样品作用前后微生物的菌落数量变化,计算抑菌率或杀菌率,常用的有振荡烧瓶法、接触法等。
- 最小抑菌浓度(MIC)测定:通过系列稀释法确定能抑制微生物生长的最低药物浓度。
不同产品需依据相应国家标准(如GB/T 20944系列)选择合适的检测方法,以确保结果的准确性和可靠性。
#检测报告 #检测 #CNAS #抑菌 #杀菌 #针织面料 #细菌 #第三方检测 #检测机构 #纺织


